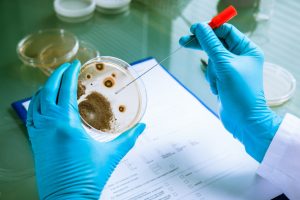

مهمترین دستگاههای آزمایشگاهی در صنایع غذایی و اهمیت تجهیزات آزمایشگاه در این صنعت
مهم ترین دستگاههای آزمایشگاهی در صنایع غذایی و اهمیت تجهیزات آزمایشگاه در این صنعت
بهطورکلی صنایع غذایی، نقشی حیاتی در سلامت و رفاه جامعه ایفا میکنند که تضمین کیفیت و ایمنی مواد غذایی از جمله اصلیترین دغدغههایی است که این صنایع با آن چالش دارند و به دنبال راهحلی برای آن میباشند.
دراینبین و برای رفع این دغدغه، آزمایشگاههایی تحت عنوان آزمایشگاه صنایع غذایی شکلگرفتهاند که یک سری تجهیزات و ابزارهای تخصصی در آن وجود دارد که نقش کلیدی برای کنترل کیفیت و ارتقای سطح سلامت جامعه ایفا میکنند. بر همین اساس در این مطلب از آروین طیف قصد داریم مهمترین دستگاههای آزمایشگاهی در صنایع غذایی را به شما معرفی کنیم و بهضرورت و اهمیت آنها در این آزمایشگاهها بپردازیم، پس تا انتهای این مطلب با ما همراه باشید.
لیست ابزارها و تجهیزات آزمایشگاه صنایع غذایی

در آزمایشگاههای صنایع غذایی، از دستگاههای مختلفی برای انجام آزمایشهای مختلف و کنترل کیفیت مواد اولیه و محصولات نهایی استفاده میشود.
شما میتوانید برای خرید تجهیزات آزمایشگاهی که در صنایع غذایی اهمیت دارند با شماره تماس های زیر در ارتباط باشید:
| شماره تماس شیراز – خط اول | 0713-235-2153 |
| شماره تماس شیراز – خط دوم | 0713-235-2164 |
| شماره موبایل | 09177509294 |
که مهمترین دستگاههای آزمایشگاهی که در صنایع غذایی مورد استفاده قرار میگیرند را میتوانیم به شرح زیر به شما معرفی کنیم:
سانتریفیوژ
این دستگاه یکی از دستگاههای کاربردی در آزمایشگاههای صنایع غذایی است که جداسازی مخلوطهای مایع – مایع و مایع – جامد را با استفاده از نیروی گریزازمرکز انجام میدهد و در صنایع غذایی بهمنظور جداسازی چربی از شیر، جداسازی آبمیوه از تفاله، جداسازی روغن از دانههای روغنی، شفافسازی آبمیوهها، تغلیظ آبمیوهها، جداسازی دو مایع با چگالیهای مختلف، هموژنیزاسیون مواد غذایی، استخراج رنگدانهها و اسانسها از مواد غذایی مورد استفاده قرار میگیرد.
رفراکتومتر
کاربرد دستگاه رفراکتومتر در آزمایشگاه صنایع غذایی اندازهگیری شاخص انکسار مواد غذایی میباشد و برای تعیین غلظت مواد مختلف مانند قند و نمک، کنترل کیفیت مواد اولیه و محصولات نهایی مورد استفاده قرار میگیرد. همچنین از این دستگاه میتوان برای تشخیص تقلبات در مواد غذایی استفاده کرد. بهعنوانمثال، میتوان از آن برای تشخیص عسل اصلی از تقلبی کمک گرفت.
ویسکوزیمتر

ویسکوزیمتر دستگاهی برای اندازهگیری ویسکوزیته یا غلظت مایعات میباشد که حضور آن در صنایع غذایی بنا به دلایل زیر بسیار بااهمیت است:
کنترل کیفیت: ویسکوزیته یکی از شاخصهای مهم سنجش کیفیت بسیاری از محصولات غذایی مانند سس، مربا، عسل، نوشیدنیها و… است که دستگاه ویسکوزیمتر این ویسکوزیته را اندازهگیری میکند و آن را با استانداردهای مربوطه مقایسه میکند و به این صورت کیفیت مواد اولیه و محصولات نهایی کنترل میشود.
فرمولاسیون: ویسکوزیته در فرمولاسیون و طراحی محصولات غذایی جدید نقش دارد که اندازهگیری میزان آن بسیار مهم میباشد.
فرایند تولید: ویسکوزیته در فرایندهای مختلف تولید مانند پمپاژ، مخلوطکردن، هموژنیزاسیون و… حائز اهمیت است و ویسکوزیمتر با اندازهگیری مقدار آن، فرایند تولید را بهینهسازی میکند.
ترازوی آزمایشگاهی
ترازوی آزمایشگاهی یکی از مهمترین و پرکاربردترین تجهیزات آزمایشگاهی صنایع غذایی میباشد که برای اندازهگیری دقیق مواد اولیه و محصولات نهایی به کار میرود. به طور مثال قبل از شروع فرایند تولید، مواد اولیه باید به طور دقیق وزن شوند تا محصولی باکیفیت نهایی تولید شود، و حتی پس از تولید نیز محصول نهایی باید وزن شود تا میزان مطابقت آن با وزن استاندارد سنجیده شود. ترازوی آزمایشگاهی برای اندازهگیری رطوبت، چربی، پروتئین و سایر مواد مغذی به کار برده شده در محصولات نیز مورد استفاده قرار میگیرد.
سمپلر
سمپلر که با نام قطعه نمونهگیر نیز شناخته میشود برای نمونهگیری از مواد غذایی در آزمایشگاهها مورد استفاده قرار میگیرد. نمونهگیری از جمله اولین اقداماتی است که برای انجام آزمایشهای مختلف و کنترل کیفیت محصولات نهایی مورد استفاده قرار میگیرد. برای انتخاب سمپلر مناسب نیز باید عواملی همچون نوع ماده غذایی، حجم نمونه، دقت سمپلر و سهولت استفاده از آن را در نظر داشته باشید.
میکروسکوپ
میکروسکوپ یکی دیگر از تجهیزات آزمایشگاه برای صنایع غذایی است که برای موارد زیادی به شرح زیر مورد استفاده قرار میگیرد:
وبسایت labcompare به طور کامل به معرفی میکروسکوپ های آزمایشگاهی پرداخته است که می توانید در صورت علاقه آن را مطالعه کنید.
کنترل کیفیت میکروبی
انواع میکروارگانیسمها مانند باکتریها، قارچها، مخمرها و ویروسها در مواد غذایی با استفاده زا میکروسکوپ شناسایی و شمارش میشوند و میزان آلودگی میکروبی مواد غذایی و ارزیابی میزان انطباق آن با استاندارها مورد بررسی قرار میگیرد.
بررسی ساختار بافتها
یکی دیگر از کاربردهای میکروسکوپ در صنایع غذایی این است که به بررسی ساختار بافت حیوانی و گیاهی همچون بافتهای حیوانی مانند گوشت، مرغ و ماهی، میوهها، سبزیجات و غلات میپردازد. این کار برای مطالعه خواص فیزیکی و شیمیایی مواد غذایی و بررسی کیفیت آنها ضروری میباشد.
بررسی آلودگیها
میکروسکوپ برای بررسی آلودگیهای میکروسکوپی مانند تخم انگل، لارو حشرات و آلودگیهای شیمیایی مانند ذرات فلزات سنگین و سموم در مواد غذایی به کار میرود. که این موضوع در تضمین سلامت و کیفیت نهایی مواد غذایی بسیار حائز اهمیت است.
آون
آون از جمله مهمترین دستگاههای آزمایشگاهی در صنایع غذایی میباشد که برای مصارف زیر مورد استفاده قرار میگیرد:
خشککردن
خشککردن ظروف شیشهای و فلزی آزمایشگاهی
خشککردن مواد غذایی برای اندازهگیری رطوبت
خشککردن مواد اولیه و محصولات نهایی برای فرایندهای مختلف
خشککردن فیلترها و کاغذ صافی
استریل کردن
استریل کردن ظروف شیشهای و فلزی آزمایشگاهی
استریل کردن مواد و محیطهای کشت میکروبی
پخت
پخت برخی از مواد غذایی برای آزمایشهای مختلف
پخت نان و کیک برای بررسی کیفیت مواد اولیه
آزمایشهای مختلف
انجام آزمایشهای تعیین نقطه ذوب
انجام آزمایشهای تعیین رطوبت
انجام آزمایشهای تعیین درصد خاکستر
انکوباتور

انکوباتور بهعنوان یکی دیگر از تجهیزات آزمایشگاهی صنایع غذایی به کشت و رشد میکروارگانیسمها در شرایط دمایی و رطوبتی مناسب میپردازد. و برای سنجش انجام موارد زیر کاربرد دارد:
کنترل کیفیت میکروبی مواد غذایی: با انکوباتور میتوان به بررسی وجود میکروارگانیسمهای بیماریزا یا فاسدکننده در مواد غذایی پرداخت.
بررسی خواص میکروبی مواد غذایی: بررسی خواص میکروبی مواد غذایی مانند تخمیر، تولید آنزیم و… توسط انکوباتور انجام میشود.
کشت میکروارگانیسمها برای تولید مواد غذایی: برای تولید برخی از مواد غذایی مانند ماست، پنیر، سس و… از میکروارگانیسمها استفاده میشود. این میکروارگانیسمها در انکوباتور کشت داده میشوند.
بررسی فساد مواد غذایی: انکوباتور برای بررسی فساد مواد غذایی و تعیین عمر مفید آنها در آزمایشگاههای صنایع غذایی کاربرد بسیاری دارد.
هیتر استیرر
هیتر استیرر یا هات پلیت مگنت، دستگاهی پر کاربرد در آزمایشگاه صنایع غذایی میباشد که بهمنظور گرمکردن و بههمزدن مواد به طور همزمان مورد استفاده قرار میگیرد.
پلاریمتر

از پلاریمتر برای اندازهگیری فعالیت نوری مواد غذایی در آزمایشگاههای صنایع غذایی استفاده میشود. بهطورکلی این دستگاه کاربردهای گستردهای در آزمایشگاههای صنایع غذایی به شرح زیر ارائه میدهد:
تعیین نوع قند موجود در مواد غذایی
ازآنجاییکه قندهای مختلف فعالیت نوری متفاوتی دارند، با استفاده از پلاریمتر میتوان نوع قند موجود در مواد غذایی را تعیین کرد.
کنترل کیفیت مواد اولیه و محصولات نهایی
میتوان از این دستگاه برای تعیین غلظت قند در آبمیوهها و نوشیدنیها استفاده کرد و کیفیت مواد اولیه و محصولات نهایی را به این شکل کنترل کرد.
تشخیص تقلبات غذایی
با استفاده از این دستگاه میتوان مواد غذایی تقلبی را شناسایی کرد. به طور مثال پلاریمتر برای تشخیص شکر تقلبی در انواع آبمیوهها و نوشیدنیها کاربرد بسیاری دارد.
دستگاه تعیین نقطه ذوب
این دستگاه همانطور که از نامش پیداست، ابزاری است که برای اندازهگیری نقطه ذوب مواد جامد در آزمایشگاههای صنایع غذایی به کار میرود. این دستگاه که جزئی جدانشدنی در آزمایشگاههای صنایع غذایی شناخته میشود، کارایی بسیاری به شرح زیر دارد:
شناسایی مواد: تعیین نقطه ذوب میتواند به شناسایی مواد ناشناخته یا تأیید هویت مواد شناخته شده در آزمایشگاه کمک بسیاری کند.
کنترل کیفیت: نقطه ذوب میتواند یک فاکتور برای کنترل کیفیت مواد اولیه و محصولات نهایی باشد، بهعنوانمثال، نقطه ذوب چربیها میتواند برای اطمینان از کیفیت آنها و عدم وجود ناخالصیها مورد استفاده قرار بگیرد.
تحقیقات و توسعه: نقطه ذوب میتواند در تحقیقات و توسعه محصولات جدید غذایی استفاده شود.
ژرمیناتور

ژرمیناتور دستگاهی است که برای جوانهزنی بذرها در شرایط کنترلشده دما، رطوبت و نور در آزمایشگاههای صنایع غذایی مورد استفاده قرار میگیرد. با استفاده از این دستگاه میتوان به بررسی قدرت جوانهزنی بذرها پرداخت و جوانههای مختلف برای مصارف خوراکی را تولید کرد.
سایر تجهیزات تخصصی آزمایشگاههای صنایع غذایی
در قسمت قبلی اصلیترین و مهمترین تجهیزات مورد استفاده در آزمایشگاههای صنایع غذایی را به تفکیک توضیح دادیم، اما علاوه بر این تجهیزات، برای داشتن یک آزمایشگاه تخصصیتر نیاز به تجهیزات بیشتری به شرح زیر میباشد:
دستگاه کروماتوگرافی مایع با کارایی بالا (HPLC): برای جداسازی و شناسایی ترکیبات مختلف در مواد غذایی، مانند ویتامینها، اسیدهای آمینه و رنگدانهها
دستگاه کجلدال: برای اندازهگیری میزان پروتئین موجود در مواد غذایی
دستگاه سوکسله: برای استخراج چربی از مواد غذایی
دستگاه اتوکلاو: برای استریل کردن تجهیزات آزمایشگاهی و مواد غذایی
اسپکتروفتومتر: برای اندازهگیری جذب نور توسط مواد غذایی و تعیین غلظت مواد مختلف
آنالایزر رطوبت: برای اندازهگیری رطوبت مواد غذایی
آنالایزر چربی: برای اندازهگیری چربی مواد غذایی
آنالایزر فیبر: برای اندازهگیری فیبر موجود در مواد غذایی
آنالایزر فلزات: برای اندازهگیری میزان فلزات موجود در مواد غذایی
دستگاههای سنجش میکروبی: برای شمارش میکروارگانیسمها در مواد غذایی
پیاچ متر: برای اندازهگیری اسیدیته یا قلیایی بودن مواد غذایی
یخچال و فریزر: برای نگهداری مواد غذایی و مواد شیمیایی
ظروف شیشهای آزمایشگاهی: برای نگهداری و مخلوطکردن مواد شیمیایی و انجام آزمایشهای مختلف
سخن پایانی

باتوجهبه اهمیت غذای سالم، نیاز به تجهیز کردن آزمایشگاههای صنایع غذایی بیشازپیش احساس میشود و برای اینکه بتوانید یک آزمایشگاه کامل و تخصصی داشته باشید، باید یک سری دستگاه کاربردی را برای خود تهیه کنید و بر همین اساس و به دلیل اهمیت این موضوع در این مطلب به معرفی این تجهیزات پرداختیم و در ادامه کاربرد تجهیزات آزمایشگاهی صنایع غذایی را یکبهیک برایتان شرح دادیم.
البته انتخاب تجهیزات مناسب برای آزمایشگاههای صنایع غذایی به عوامل مختلفی مانند نوع آزمایش، محصول موردنظر، بودجه و فضای آزمایشگاه بستگی دارد و شما میتوانید اکثر این تجهیزات را متناسب با نیاز و بودجهتان از شرکت تخصصی آروین طیف خریداری کنید.
همینطور جهت آشنایی با دلایلی که باعث می شود که آزمایشگاه های صنایع غذایی از اهمیت بالایی برخوردار باشند به مقاله وبسایت baliseafoodlab سر بزنید.
حتی قبل از خرید نیز میتوانید با کارشناسان و مشاوران متخصص آن تماس بگیرید و راهنماییهای لازم را دریافت کنید، زیرا انتخاب صحیح تجهیزات، تضمینکننده دقت و صحت آزمایشها، افزایش راندمان و بهرهوری، و در نهایت ارتقای کیفیت محصولات نهایی خواهد بود و اگر شما این محصولات را با آگاهی قبلی و از یک مرجع معتبر خریداری کنید، به طبع محصولات نهایی باکیفیتتری را ارائه میدهید و نقشی مهم در مسیر پیشرفت صنایع غذایی و پاسخگویی به نیازهای روزافزون مشتریان خواهید داشت.
اولین دیدگاه را ثبت کنید